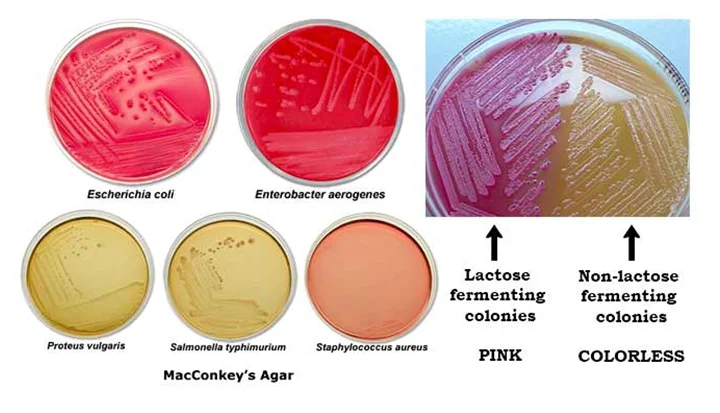
مورفولوژی کلنی در مک کانکی آگار

مقدمهای بر مک کانکی آگار
مک کانکی آگار (MAC) اولین محیط افتراقی (تشخیصی) جامد بود که در قرن بیستم توسط آلفرد تئودور مک کانکی ساخته شد. مک کانکی آگار یک محیط انتخابی و متمایز است که برای جداسازی و تمایز باسیل گرم منفی غیر مستحکم، به ویژه اعضای خانواده انتروباکتریاسه (Enterobacteriaceae) از جنس/سرده سودوموناس (Pseudomonas) استفاده میشود.
ترکیبات مک کانکی آگار

اساس مک کانکی آگار
مک کانکی آگار برای جداسازی باکتریهای رودهای (گوارشی) گرم منفی و تمایز باکتریهای گرم منفی تخمیری و غیر تخمیری لاکتوز استفاده میشود. هضم پانکراس ژلاتین و پپتونها (گوشت و کازئین) مواد مغذی ضروری، ویتامینها و عوامل نیتروژنی مورد نیاز برای رشد میکروارگانیسمها را فراهم میکند.
لاکتوز مونوهیدرات منبع قابل تخمیر کربوهیدرات است. عمل انتخابی این محیط به کریستال ویولت و نمکهای صفراوی آن نسبت داده میشود که برای اکثر گونههای باکتریهای گرم مثبت نقش مهار کننده دارد. کلرید سدیم تعادل اسمزی را در محیط حفظ میکند. نوترال رد (Neutral red)یک نشانگر PH است که در pH کمتر از ۶٫۸ قرمز میشود و در هر pH بیشتر از ۶٫۸، بیرنگ است. آگار عامل انسجام است.
موارد استفاده از مک کانکی آگار
- مک کانکی آگار برای جداسازی باکتریهای رودهای گرم منفی استفاده میشود.
- در تمایز باکتریهای گرم منفی تخمیری و غیر تخمیری لاکتوز استفاده میشود.
- برای جداسازی کلیفرمها و پاتوژنهای رودهای (گوارشی) موجود در آب، محصولات لبنی و نمونههای بیولوژیکی استفاده میشود.
تهیه مک کانکی آگار
- ۴۹٫۵۳ گرم از محیط کشت خشک را در ۱۰۰۰ میلیلیتر آب تصفیه شده/مقطر حل کنید.
- ترکیب را حرارت دهید تا به جوش آید و کاملاً حل شود.
- با اتوکلاو کردن (۱۲۱ درجه سانتیگراد) به مدت ۱۵ دقیقه استریل کنید.
- اجازه دهید تا دمای ۴۵ الی ۵۰ درجه سانتیگراد خنک شود.
- قبل از ریختن در پتری دیشهای استریل، به خوبی مخلوط کنید.
تفسیر نتایج در مک کانکی آگار
سویههای تخمیر کننده لاکتوز به رنگ قرمز یا صورتی رشد میکنند و ممکن است توسط ناحیهای از صفرای رسوب شده با اسید احاطه شوند. رنگ قرمز ناشی از تولید اسید از لاکتوز، جذب نوترال رد و متعاقباً تغییر رنگ در زمانی است که PH محیط به زیر ۶٫۸ میرسد.
سویههای غیر تخمیری لاکتوز مانند شیگلا و سالمونلا بیرنگ و شفاف هستند و معمولاً ظاهر محیط را تغییر نمیدهند. یرسینیا انتروکولیتیکا ممکن است پس از انکوبه شدن در دمای اتاق به صورت کلنیهای کوچک تخمیری غیر لاکتوز ظاهر شود.
مورفولوژی کلنی در مک کانکی آگار

محدودیتهای مک کانکی آگار
- ویژگیهای کلنیهای توصیف شده، تنها ارگانیسمهای جدا شده را به صورت احتمالی شناسایی میکنند. برای شناسایی نهایی لازم است از ریزکشت (کشت فرعی) استفاده شود و تستهای تأییدی انجام شود.
- ممکن است با برخی از سویهها مواجه شوید که رشد ضعیفی دارند یا در این محیط رشد نمیکنند.
- اینطور گزارش شده است که انکوباسیون پلیتهای مک کانکی آگار تحت افزایش CO2 باعث کاهش رشد و بازیابی تعدادی از سویههای باسیلهای گرم منفی میشود.
- برخی از سویههای پروتئوس ممکن است به این محیط کشت هجوم بیاورند.
جهت خرید و یا استعلام قیمت با ما تماس بگیرید یا در واتسپ پیام بزارید
مطالب مرتبط:
- بروسلا آگار (Brucella Agar): ترکیب، اصول، روش آمادهسازی، نتایج و کاربرد
- اندو آگار (Endo Agar): ترکیب، اصول، روش آمادهسازی و کاربرد
- آگار CLED: ترکیب، اصول، روش تهیه، نتایج و کاربرد
- مانیتول سالت آگار (محیط کشت MSA): ترکیبات، کاربرد، تهیه
- سابورو دکستروز آگار (SDA): ترکیب، اساس، کاربرد، تهیه و مورفولوژی کلنی
- آگار SCA (نشاسته کازئین آگار): ترکیب، کاربردها، آماده سازی و تفسیر
مترجم: مریم محجوب